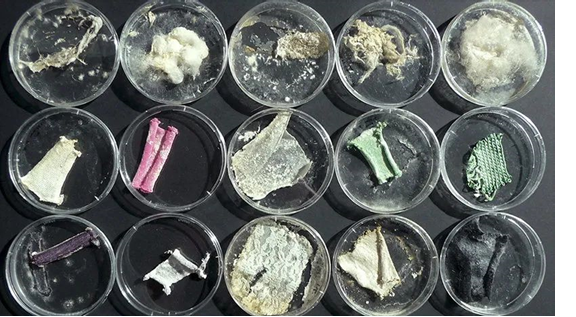
圖片關(guān)鍵詞

圍觀!國外的這種“黑科技”服裝面料你們見過嗎?
發(fā)布時間:2021-03-09

隨著消費者的環(huán)保意識日益提升,從奢侈時尚品牌到高街品牌,大家都在采取措施以減少浪費。近日,全球第二大快時尚零售商 H&M 表示,它將在瑞典的一家門店展示一臺回收機,可以將舊套頭衫當場變成新毛衣或新圍巾。

荷蘭創(chuàng)業(yè)公司 MycoTEX的創(chuàng)始人阿涅拉從另一個角度思考了這些問題,她認為服裝可以以一種更具有生物生命周期的方式存在,衣服的生產(chǎn)和填埋可以像樹木的生長和落葉一樣,實現(xiàn)真正的循環(huán)。
據(jù)了解,阿涅拉用菌絲體(蘑菇的代謝組織)生產(chǎn)按需定制的服裝,以減少浪費和化學品的使用。這些由蘑菇制成的衣服至少可穿著兩年,在使用壽命結(jié)束時,它將是完全可生物降解的。
MycoTEX面料上生長的菌絲體
阿涅拉表示,從培養(yǎng)菌絲體、收獲菌絲體,到將其放入3D模具、干燥,直至完成最終產(chǎn)品,菌絲體的生產(chǎn)周期目前大約需要兩到三個星期。特別值得一提的是,這種材料還可以為不同體型和不同市場的顧客塑造量身定制的服裝。
(來源:CFW時尚)
